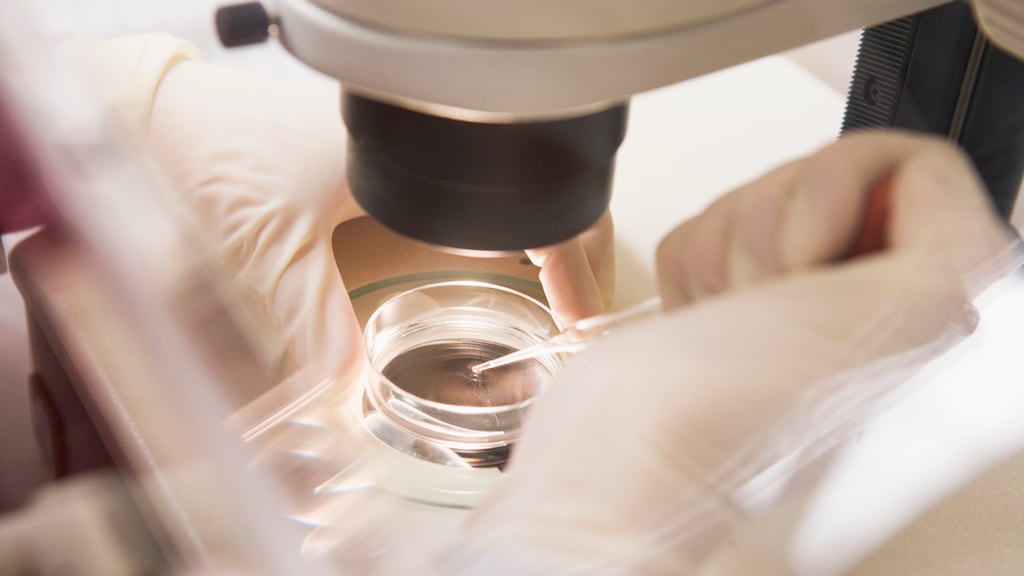
Lagerhuis stemt in met wet voor embryo met drie ouders

Wereldprimeur: eerste 'bouwpakketbaby' uit drie ouders in de maak

Volgend jaar zullen de eerste baby's uit drie ouders worden geboren. Volgens artsen een wereldprimeur én een uitkomst voor honderden vrouwen met een erfelijke ziekte.
In Groot-Brittannië is het al bijna zover. "En we verwachten dat binnen een paar jaar ook in Nederland de eerste bouwpakketbaby geboren zal worden uit drie ouders", vertelt hoogleraar genetica Bert Smeets. "Een wereldprimeur."
Stofwisselingsziekte
Dat is goed nieuws voor vrouwen met een erfelijke stofwisselingsziekte. Door deze nieuwe techniek geeft deze groep vrouwen hun ernstige ziekte niet meer door aan hun kind. Smeets licht toe: "Simpel gezegd werkt de celkerntransplantatieals volgt: de donormoeder geeft eicellen af. Daar halen artsen de eicelkern uit. Die eicelkern zetten ze in de eicel van de echte moeder. Daardoor worden de organellen waarin de erfelijke ziekte zit niet overgedragen aan de baby en wordt die dus gezond geboren. "
Volgens Smeets zijn enkele honderden vrouwen hiermee geholpen. Deze vrouwen hebben een afwijking in de mitochondriën van de cellen, waardoor ze een ernstige en vaak dodelijke stofwisselingsziekte ontwikkelen.
Wet
De Nederlandse wet staat het al toe om een baby uit drie ouders te verwekken. "Nederlandse artsen beheersen de techniek alleen nog niet, maar dat kan snel opgelost worden door artsen richting Engeland te sturen zodat ze de techniek onder de knie krijgen. We verwachten deze techniek ook snel in ons land toe te passen", zegt Cor Oosterwijk, directeur van de koepelorganisatie voor patiënten met een erfelijke aandoening.
De techniek roept wel ethische vragen op. Critici laken de wijze waarop baby's als bouwpakket in elkaar worden geknutseld. Volgens Oosterwijkmoet de celkerntransplantatievergeleken worden met orgaandonatie. "De baby heeft wat celcompartimenten van een andere moeder gekregen, maar dat isnauwelijks relevant voor wie de baby is en hoe zijn karakter is."
Meer op rtlnieuws.nl:
Eerste verjaardag voor baby die geboorte niet zou overleven
Onderdeel van dossier
Driepersoonsembryo's